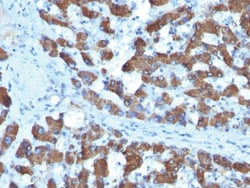
CPS1 / Carbamoyl-Phosphate Synthetase Mouse, Clone: SPM615, enQuireBio

missing translation for 'onlineSavingsMsg'
Learn More
Learn More
CPS1 / Carbamoyl-Phosphate Synthetase Mouse, Clone: SPM615, enQuireBio™
Mouse Monoclonal Antibody
Brand: EnquireBio 1373-MSM1X-P1
This item is not returnable.
View return policy
Specifications
| CPS1 / Carbamoyl-Phosphate Synthetase | |
| Finely granular cytoplasmic | |
| SPM615 | |
| Unconjugated | |
| XP_011508945 | |
| Mouse | |
| ∽165kDa | |
| Protein A/G Purified | |
| RUO | |
| 1373 | |
| IgG1 |
| Immunofluorescence, Immunohistochemistry | |
| Monoclonal | |
| 200μg/mL | |
| 10mM PBS with 0.05% BSA and 0.05% azide | |
| CPS1 | |
| Recombinant human CPS1 protein | |
| HeLa cells. Liver or Hepatocellular Carcinoma (HCC) | |
| 100 μg | |
| Primary | |
| Short term: Store at 2-4°C. Long term, aliquot and store at -20°C. |
Product Content Correction
Your input is important to us. Please complete this form to provide feedback related to the content on this product.
Product Title
Spot an opportunity for improvement?Share a Content Correction